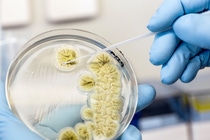

Spain
La estrategia de BASF para la agricultura se orienta al crecimiento basado en la innovación en mercados específicos
- Una atractiva oferta que combina semillas, genética, protección de cultivos y soluciones digitales para contribuir al éxito del agricultor a nivel mundial
- Previsión de un crecimiento rentable de un 1% por encima del mercado agrícola global y un incremento de las ventas de un 50% para el 2030
- Lanzamiento de más de 30 nuevos productos para 2028 con un potencial de ventas de más de 6.000 millones de euros
- Incremento de ventas de productos que contribuyen sustancialmente a sostenibilidad
BASF Agricultural Solutions está enfocada a un incremento en su cuota de mercado y un crecimiento de un 1% por encima del mercado agrícola. Para 2030, la división aspira a un incremento del 50% en sus ventas. Esto contribuirá significativamente al objetivo de crecimiento del Grupo BASF, fijado en de 22 millardos de euros en ventas para 2025, con productos que contribuyen sustancialmente a la sostenibilidad en la cadena valor. Se prevé un incremento del EBITDA antes de extraordinarios de BASF Agricultural Solutions de un 5% de media por año.
“Hay una demanda creciente por parte de agricultores, legisladores y consumidores a nivel mundial para que BASF aporte valor a la sociedad – a nivel financiero, social y medioambiental. Con nuestra estrategia innovadora en la agricultura, estamos dando un paso adelante hacia este reto, centrándonos en las necesidades de nuestros clientes y de la sociedad. Confiamos en encontrar el equilibrio justo para el éxito – para los agricultores, para la agricultura y para las generaciones futuras”, ha señalado hace unos días Saori Dubourg, miembro del Consejo de Administración, en el Capital Markets Day en el Centro de Innovación Agrícola de BASF en Ghent, Bélgica.
La estrategia de BASF para la agricultura se basa en innovaciones que permiten a los agricultores alimentar a una población en aumento y afrontar retos como las limitadas superficies de tierras cultivables, la presión de las enfermedades y el cambio climático. Un incremento del presupuesto en I+D de casi 900 millones de euros en 2019 está reforzando la cartera de productos en desarrollo para la agricultura. Para 2028 BASF lanzará más de 30 nuevos productos con un potencial de ventas máximo de 6.000 millones de euros. Esto incluye ocho nuevos ingredientes activos, así como rasgos genéticos y semillas de alto rendimiento en trigo híbrido, soja, colza, algodón y hortalizas. BASF está dirigiendo activamente su oferta a los agricultores y a la industria agrícola hacia soluciones sostenibles, teniendo en cuenta la sostenibilidad en todas sus decisiones de negocio y de portfolio. “Los criterios de sostenibilidad son parte integrante de toda la fase de I+D para identificar y desarrollar aquellos compuestos que benefician tanto a los agricultores como al medio ambiente”, ha expuesto Peter Eckes, responsable de Bioscience Research de BASF.
Fortaleciendo la experiencia del cliente
“Con nuestra estrategia, estamos abriendo un nuevo capítulo que pone el negocio del agricultor en el centro de todo lo que hacemos”, ha señalado Vincent Gros, Presidente de la División Agricultural Solutions de BASF. “Los agricultores trabajan cultivos diferentes con ciclos de crecimiento y necesidades diferentes. Es por ello que nos enfocamos en determinados sistemas de cultivos donde tenemos una oferta atractiva. De este modo, podemos dar el mejor apoyo a nuestros clientes para maximizar sus cosechas, mitigando los riesgos meteorológicos y la presión de las enfermedades, así como ayudarles a cumplir los requerimientos de la sociedad.”
“Los agricultores de la subregión Europa Sur podrán comprobar los elevados estándares de sostenibilidad gracias a soluciones innovadoras como Provisia®, Revysol® Tessior® y Fibermax®. Asimismo, tendrán acceso a ofertas personalizadas en semillas de hortalizas y algodón, así como en soluciones digitales. “Nuestro objetivo es crecer de forma rentable manteniendo el foco en cumplir con los requisitos sociales y medioambientales”, confirma Alberto Ancora, Vicepresidente de Agricultural Solutions EMEA South.
Tras la exitosa integración estructural de los negocios y activos adquiridos a Bayer hace menos de un año, BASF puede ahora proveer a los agricultores con un catálogo combinado de soluciones agrícolas desde semillas, rasgos genéticos, protección de cultivos y hasta soluciones digitales. Como una de las compañías líderes en soluciones agrícolas a nivel mundial, BASF centra sus actividades en cuatro segmentos estratégicos de clientes según sus cultivos: soja, maíz y algodón en las Américas; trigo, colza y girasol en América del Norte y Europa; arroz en Asia; frutales y hortalizas a nivel global. En total, estos cultivos representan aproximadamente el 70% del mercado global.
BASF creará nuevas fuentes de ingresos con las soluciones digitales en la agricultura. Gracias a una experiencia pionera en el ámbito digital en la agricultura, así como al sólido compromiso con sus socios, la compañía ofrecerá soluciones digitales que añaden valor a la forma en que los agricultores aplican los productos de BASF, a como gestionan sus tierras, así como a la manera en que acceden y compran productos o servicios. Además, BASF aplicará tecnologías de precisión y digitalización para aprovechar futuras oportunidades de innovación en agricultura. Esto incluye nuevos modelos de negocio basados en resultados.
Incremento considerable de ventas y EBIT antes de extraordinarios en el primer semestre de 2019
En el primer semestre de 2019, la división Agricultural Solutions aumentó en un 38% sus ventas en comparación con el mismo período del año anterior, hasta alcanzar los 4.400 millones de euros. Ello se debe principalmente a los efectos provenientes de la adquisición de los negocios y activos de Bayer en agosto de 2018. El EBIT antes de extraordinarios de Agricultural Solutions alcanzó el 23% hasta llegar a 861 millones de euros en el primer semestre de 2019, principalmente debido a la contribución de los negocios adquiridos.
Información sobre la División de Protección de Cultivos de BASF
Con una población mundial en constante y rápido crecimiento, el planeta depende cada vez más de nuestra capacidad de hacer agricultura de forma sostenible y de mantener sano el medio ambiente. La División de Protección de Cultivos de BASF trabaja con agricultores, profesionales del sector agrícola, expertos en control de plagas y otros para que esto se haga realidad. Por esta razón BASF invierte fuertemente en I+D y en una amplia cartera de productos, que incluye semillas, protección de cultivos química y biológica, gestión del suelo, sanidad vegetal, control de plagas y soluciones digitales para la agricultura. Gracias a equipos altamente profesionales trabajando tanto en laboratorio como en campo, en las oficinas, así como en la producción, BASF es capaz de conectar conceptos innovadores con acciones concretas para dar forma a ideas que tengan aplicación y éxito reales – para los agricultores, la sociedad y el planeta. En 2018 la División de Protección de Cultivos de BASF generó un volumen de negocio de 6.200 millones de €. Puede encontrar más información en la web www.agriculture.basf.com o a través de nuestras redes sociales.
Acerca de BASF
En BASF, creamos química para un futuro sostenible. Combinamos el éxito económico con la responsabilidad social y la protección del medio ambiente. El Grupo BASF cuenta con aproximadamente 122.000 colaboradores que trabajan para contribuir al éxito de nuestros clientes en casi todos los sectores y países del mundo. Nuestra cartera está organizada en seis segmentos: Productos Químicos, Materiales, Soluciones Industriales, Tecnologías de Superficie, Nutrición & Cuidado y Soluciones Agrícolas. En 2018, BASF generó unas ventas de unos 63.000 millones de euros. Las acciones de BASF cotizan en la bolsa de Frankfurt (BAS) y como American Depositary Receipts (BASFY) en EE.UU. Más información en www.basf.com.